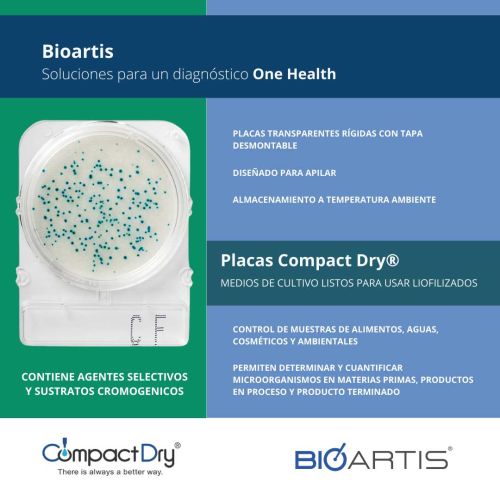

Sistema automático para detección de patógenos en alimentos
Detección microbiana avanzada para análisis de patógenos y de control de calidad en alimentos
Análisis de PCR en Tiempo Real, múltiple detección de marcadores y diferenciación cuantitativa de especies hacen del Sistema BAX® Q7 de DuPont Qualicon, el más avanzado sistema de detección con base en ADN disponible.

Incorporando la innovativa tecnología para PCR de Applied Biosystems, el nuevo Sistema BAX ® Q7 ofrece avanzada detección con base en ADN para una amplia variedad de aplicaciones de muestreo – desde ingredientes hasta productos terminados
La avanzada tecnología del nuevo Sistema BAX® Q7
Capacidad avanzada para futuros ensayos Sistema BAX®:
Proceso más rápido— menos de 2 horas
Cinco marcadores para detección de múltiples objetivos en un mismo pozo
Análisis más allá de presencia / ausencia, por ejemplo cuantificación ó diferenciación de especies.
Capacidad para PCR en Tiempo Real
Compatibilidad total con los actuales ensayos Sistema BAX®
Componente clave del futuro sistema integrado para análisis de alimentos análisis automatizados
Resultados rápidos
Mínimo tiempo de manipulación usando técnicas estándar de laboratorio
Plataforma y protocolo de amplificación únicos permiten elmanálisis de varios objetivos en una misma corrida
Alta capacidad de carga, 96 muestras por corrida
Productividad y beneficio costo - eficiencia superior
Tabletas para PCR pre-empacadas, incluyendo un control interno y los ingredientes para evitar la inhibición del PCR
Licencia para realización de PCR incluida en el precio de compra
Grabación electrónica de la información para fácil almacenamiento, recuperación e impresión

Desempeño comprobado
Exactitud — excelente inclusividad y exclusividad para todos los objetivos
Certeza — resultados claros y reproducibles, independientemente de la técnica del operador
Confiabilidad — amplificación, detección y análisis automatizados
Sistema completo para uso más fácil
Componentes del Sistema incluyen: Termociclador / detector de la serie Q7, aplicación Sistema BAX®, computador, impresora, instalación, entrenamiento, documentación, y paquete de arranque con equipo y consumibles.

Kits disponibles
-
D11801836BAX E. sakazakii -
D12683449BAX Campylobacter REAL TIME -
D12404903BAX E. coli O157:H7 MP -
D14203648BAX E. coli O157:H7 REAL TIME -
D12522091BAX Hongos y levaduras -
D11000147BAX Listeria género -
D13608135BAX Listeria género 24E -
D15131113BAX Listeria género REAL TIME -
D11000157BAX Listeria mono -
D13608125BAX Listeria mono 24E -
D15134303BAX Listeria mono REAL TIME -
D11000133BAX Salmonella -
D14368501BAX Salmonella 2 -
D14306040BAX Salmonella REAL TIME -
D12762689BAX Staphylococcus aureus -
D14642970BAX STEC PANEL 1 REAL TIME (O26 - O111 - O121) -
D14642987BAX STEC PANEL 2 REAL TIME (O45 - O103 - O145) -
D14642964BAX STEC Screening REAL TIME (stx- eae)